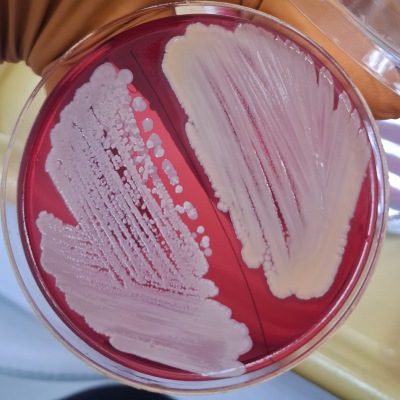
3
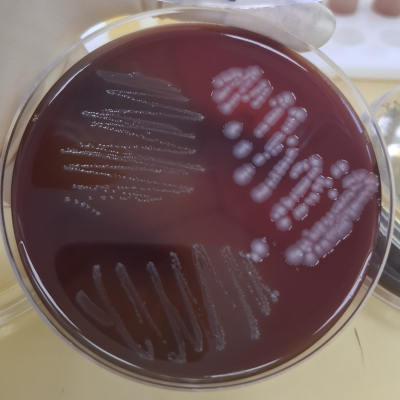
5

В целях повышения качества проводимых испытаний и контроля их достоверности специалисты Краснодарской испытательной лаборатории ФГБУ «ВНИИЗЖ» регулярно участвуют в межлабораторных сравнительных испытаниях (далее-МСИ).
20.04.2026 получено заключение по итогам успешного прохождения МСИ, окончательный отчёт № 1/1-2026 от 20.04.2026, по программам А/3-26 «Видовая идентификация возбудителей бактериальных инфекций» и А/6-26 «Гельминтозы и протозоозы животных и птиц».
В качестве образцов контроля были представлены имитанты биологических материалов животных: 17 проб лиофилизированных штаммов микроорганизмов для определения родовой и видовой идентификации согласно действующим методическим указаниям по диагностике стафилококкоза, листериоза, стрептококкоза, колибактериоза, псевдомоноза, сальмонеллёза, смешанной кишечной инфекции и пастереллёза.
Идентификация бактерий проводилась в 3 этапа:
Идентификация паразитарных объектов проводилась микроскопическим методом.
Результаты исследований признаны удовлетворительными.
Специалисты отдела бактериологии, паразитологии и питательных сред в очередной раз подтвердили свою компетентность и профессионализм в ходе проведения диагностики бактериальных и паразитарных болезней животных.
Полученная оценка результатов МСИ свидетельствует о высоком уровне достоверности лабораторных испытаний, проводимых в Краснодарской испытательной лаборатории.